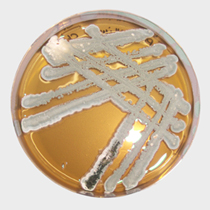

Mikrobiologie, Reinraumkontamination, Monitoring, Dekontaminationsmaßnahmen
Inhalte & LernzieleBakterien, Pilze, Sporen und Viren stellen ein maßgebliches Risiko für Produkte und Prozesse innerhalb von Reinräumen dar. Eventuelle Kontaminationsquellen zu erkennen und die Produktqualität wirkungsvoll zu kontrollieren ist eine Grundforderung des Qualitätsmanagementsystems GMP, um die Patientensicherheit zu gewährleisten. Dieser Kurs vermittelt Ihnen die notwendigen Kenntnisse über Art und Eigenschaften dieser Kontaminationen, ihre Eintritts-Wege in die kontrollierten Bereiche und Reinräume sowie die Möglichkeiten sicherer Nachweise. Prävention, Sterilisation und Dekontamination werden intensiv beleuchtet, inklusive einer verständlichen Abgrenzung gegenüber der Schädlingsbekämpfung (pest control). |
![]() |
Themen des Theorie-Seminars
|
|
Erweiterungsthemen bei In-house Schulungen
Diese Inhalte werden bei In-house Kursen je nach Bedarf und Kundenwunsch angepaßt, ergänzt und gekürzt. Weitere Themen könnten z.B. sein
Zielgruppe
In-house: Dieser Kurs ist 2-tägig angelegt, wird jedoch je nach Kundenvorgabe für Wiederholungsschulungen und Doktoranden auf 1 Tag gekürzt oder mit dem GMP Basiskurs kombiniert und auf 4 Tage ausgeweitet. Ihre besonderen Wünsche und Anforderungen besprechen wir vorab in einem zwanglosen und unverbindlichen Telefonat. Unsere Kontaktdaten finden Sie hier.
Termine und Preise
Für In-house Schulungen kontaktieren sie uns gerne per mail oder telefonisch, dann erstellen wir Ihnen ein individuelles Angebot, das sich nach den Inhalten und der Dauer des In-house Kurses richtet. Bereits ab 4-5 Teilnehmern ist ein In-house-Kurs günstiger als die individuelle Schulung ihrer Mitarbeiter durch Teilnahme an offenen Fortbildungen. Den Termin der Schulung sprechen wir natürlich mit Ihnen ab. Generell kann ein Kurs innerhalb von 4-8 Wochen nach dem Erstkontakt bei Ihnen durchgeführt werden. Ihre besonderen Wünsche und Anforderungen besprechen wir vorab in einem zwanglosen und unverbindlichen Telefonat. Unsere Kontaktdaten finden Sie hier.
Die Kursgebühr bei In-house Schulungen beinhaltet die Schulungsunterlagen im Farbdruck, ein Teilnahme-Zertifikat sowie die Reise- und Hotelkosten der Dozentin oder des Dozenten.
Vorteile von In-house Schulungen
- Ab 4-5 Teilnehmern ist eine In-house Schulung günstiger
- Ihre Mitarbeiter müssen nicht reisen
- Das Trainingskonzept wird individuell für sie zusammengestellt und an Ihre Ziele und Mitarbeiter angepasst
- In Praxisschulungen kann Ihr Assay im Kurs durchgeführt werden, dies hilft beim trouble shooting
- Alle Mitarbeiter Ihrer Abteilung sind an der Entwicklung neuer Standards aktiv beteiligt. Dies erhöht die Compliance
- Die Praxisteile finden in Ihren Laboren statt und alle Ergebnisse sind direkt übertragbar
- Optimierungsvorschläge sind so auch bei Räumen und Abläufen möglich
Kursstruktur und Planung:
- Kursbeginn (am ersten Tag) 09:00 Uhr
- Kursende (bei eintägigen Kursen) ca. 17:00
- Kursende (bei mehrtägigen Kursen bis zum vorletzten Tag) ca. 17:00 Uhr
- Kursende (bei mehrtägigen Kursen am letzten Tag) ca. 16:00 Uhr
Ort des Trainings
Diesen Kurs führen wir gerne in ihren Räumen durch.
- In-house Kurse: wir kommen zu Ihnen - die Wahl für mehrere Personen aus einem Unternehmen
Trainingsarten: Theorie und Praxis
Um ein effektives Lernen zu fördern, versuchen wir immer Theorieteile und Praxisteile in einem Kurs miteinander zu kombinieren. So kann das neu Erlernte im Labor direkt in die Praxis umgesetzt werden. Feed-back und praktische Übungen helfen dabei, den Lernerfolg zu vertiefen und direkt in Abläufe zu integrieren. Wenn sie jedoch Ihren Mitarbeitern und Kollegen schnell einen Überblick über viele Themen geben wollen, können diese Themen auch in einem Theorie-Seminar interaktiv bearbeitet werden.
- Theorie: Offener Kurs und In-house Schulungen
- Praxis: Offener Kurs und In-house Schulungen
Dozent
|
Herr Wolf-Dieter Wanner studierte Pharmazie an der LMU in München, arbeitete zunächst in einer Apotheke und wechselte 1986 zu Henkel KGaA in Düsseldorf. Dort baute er den Geschäftsbereich für Reinraumaufbereitung und Personalhygiene auf. Ab 1990 war er zusätzlich als Hygienereferent tätig. 2000 übernahm er die Leitung des Healthcare Industriegeschäftes in der Ecolab Deutschland GmbH mit Fokus auf die pharmazeutische Industrie. Nach Zukauf zweier britischer Hersteller aseptischer Produkte, integrierte er diese zusammen mit dem deutschen Pharmageschäft, in ein internationales Cleanroom Team mit Schwerpunkt auf die aseptische Herstellung. Seit 2011 ist Herr Wanner selbstständiger Berater, Trainer und Vortragender in Deutschland sowie in der Schweiz. Im Auftrag zahlreicher Fortbildungsdienstleister (Concept Heidelberg, Swiss Cleanroom Concept, PromoCell Academy, PCS the Compliance Company, etc.) ist er als Referent in Seminaren tätig. In Inhouse Trainings schult er direkt Mit-arbeiter von pharmazeutischen Herstellungsbetrieben, Klinikapotheken (Zytostatika), Reinraumdienstleistern und nichtpharmazeutischen Reinraumbetreibern. |
![]() |